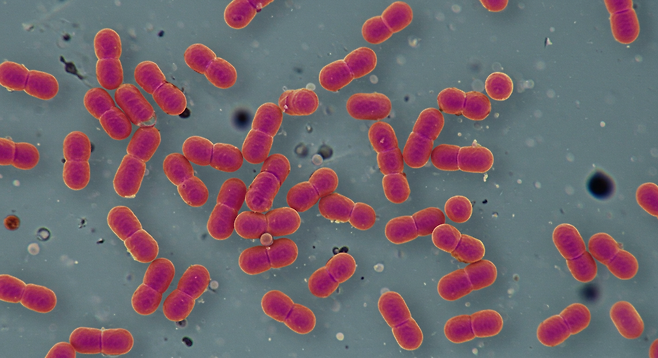

당신의 00, 화장실보다 더러울 수도 있다

매일 식탁을 깨끗하게 닦기 위해 사용하는 행주. 하지만 이 행주가 오히려 우리 가족의 건강을 위협하고 있다는 사실을 알고 계신가요?
미국미생물학회가 발표한 연구 결과는 충격적입니다. 한 달간 사용한 행주 100개를 조사한 결과, 절반에 가까운 49개에서 식중독을 유발하는 위험한 세균들이 발견되었습니다. 대장균이 36.7%, 장구균이 30.6%나 검출된 것입니다.
더욱 놀라운 사실은 젖은 행주의 세균 증식 속도입니다. 젖은 행주를 상온에 그대로 두면 6시간 후부터 세균이 번식하기 시작해, 12시간 후에는 세균 수가 무려 100만 배까지 증가합니다.

우리 집 행주 사용법, 과연 안전할까?
국내 조사에 따르면 응답자의 62.6%가 주방에서 단 한 장의 행주만 사용하고 있습니다. 용도별로 구분해서 사용하는 사람은 고작 11%에 불과했죠.
행주 하나로 이 모든 일을 한다고?
▷ 식사 전후 식탁 닦기 (76.2%)
▷ 주방기구 청소 (57.6%)
▷ 설거지 후 식기 물기 제거 (44.4%)
▷ 조리 시 손 닦기 (31.8%)
▷ 음식 재료의 피나 수분 제거 (17.2%)
이렇게 다양한 용도로 사용하면서 세균의 교차오염은 피할 수 없게 됩니다. 오염된 행주의 세균 중 5~10%가 도마, 칼 등 다른 조리도구로 옮겨간다는 연구 결과도 있습니다.
10명 중 7명이 틀린 행주 보관법
더 심각한 문제는 행주 관리 방법입니다. 조사 결과 응답자의 82.2%가 행주를 젖은 상태로 사용하고, 10명 중 7명은 사용 후 제대로 건조시키지 않고 수도꼭지나 싱크대에 그냥 걸어둡니다.
실제로 위생수칙을 제대로 지키며 행주를 관리하는 사람은 단 5.4%에 불과했습니다. 나머지 94.6%는 모르는 사이에 세균 덩어리로 식탁을 닦고 있는 셈입니다.

전문가가 제안하는 해결책
그렇다면 어떻게 해야 할까요? 전문가들은 다음과 같은 대안을 제시합니다.
일회용 키친타월 활용
교차오염을 완전히 차단할 수 있는 가장 확실한 방법입니다. 특히 고기나 생선을 다룬 후에는 반드시 일회용 제품을 사용하세요.
빨아쓰는 위생행주
몇 번 사용 후 버릴 수 있어 위생적이면서도 경제적입니다. 일반 행주보다 관리가 쉽고 안전합니다.
용도별 행주 분리
만약 일반 행주를 계속 사용한다면 최소한 식기용, 식품용, 싱크대용, 식탁용으로 나누어 사용하고, 매일 끓는 물에 10분 이상 삶아 소독해야 합니다.

작은 변화가 만드는 큰 차이
세계보건기구 자료에 따르면 식중독의 약 25%는 조리 도구에서 균이 옮겨져 생기는 2차 감염 때문입니다. 행주 하나만 제대로 관리해도 우리 가족의 건강을 크게 지킬 수 있다는 뜻입니다.
오늘부터라도 행주 사용법을 점검해보세요. 깨끗하다고 생각했던 그 행주가 실은 세균의 온상일 수도 있으니까요.
Copyright © 반딧불